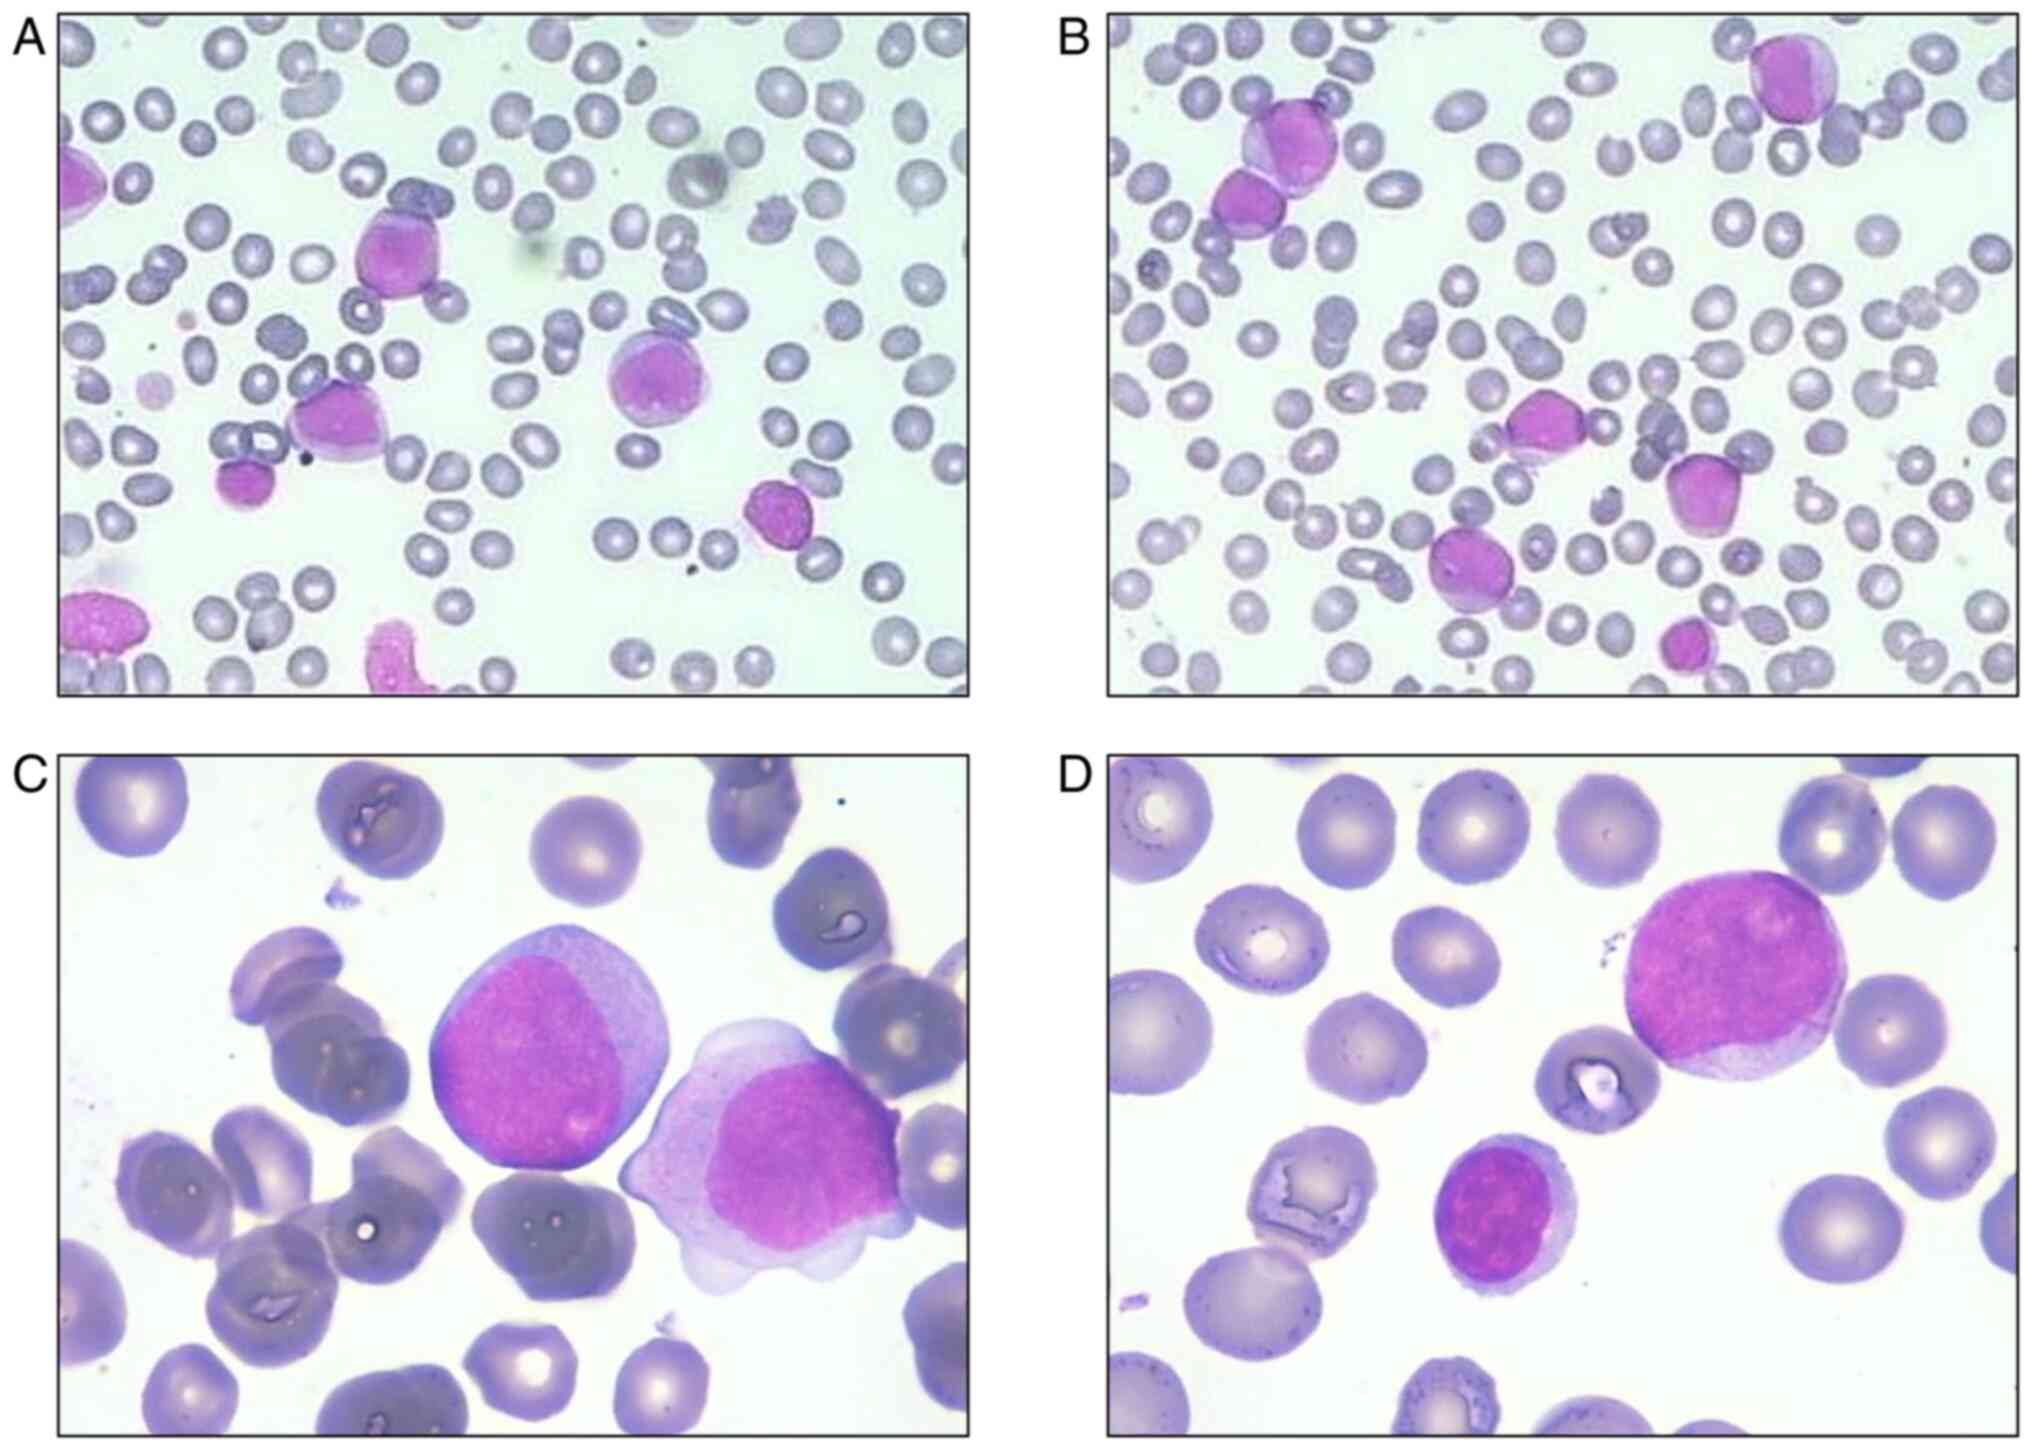

|
1
|
Hallek M and Al-Sawaf O: Chronic
lymphocytic leukemia: 2022 update on diagnostic and therapeutic
procedures. Am J Hematol. 96:1679–1705. 2021. View Article : Google Scholar : PubMed/NCBI
|
|
2
|
Tadmor T and Polliack A: Optimal
management of older patients with chronic lymphocytic leukemia:
Some facts and principles guiding therapeutic choices. Blood Rev.
26:15–23. 2012. View Article : Google Scholar : PubMed/NCBI
|
|
3
|
Schöllkopf C, Rosendahl D, Rostgaard K,
Pipper C and Hjalgrim H: Risk of second cancer after chronic
lymphocytic leukemia. Int J Cancer. 121:151–156. 2007. View Article : Google Scholar : PubMed/NCBI
|
|
4
|
Tambaro FP, Garcia-Manero G, O'Brien SM,
Faderl SH, Ferrajoli A, Burger JA, Pierce S, Wang X, Do KA,
Kantarjian HM, et al: Outcomes for patients with chronic
lymphocytic leukemia and acute leukemia or myelodysplastic
syndrome. Leukemia. 30:325–330. 2016. View Article : Google Scholar : PubMed/NCBI
|
|
5
|
Niscola P, Noguera NI, Catalano G, Cupelli
L, Fratoni S, Giovannini M, Mazzone C, Neri B, Scaramucci L,
Trawinska MM, et al: Double remission of simultaneously occurring
secondary AML and CLL by venetoclax monotherapy. Acta Oncol.
58:888–8890. 2019. View Article : Google Scholar : PubMed/NCBI
|
|
6
|
Xu Y and Ye H: Progress in understanding
the mechanisms of resistance to BCL-2 inhibitors. Exp Hematol
Oncol. 11:312022. View Article : Google Scholar : PubMed/NCBI
|
|
7
|
Del Poeta G, Venditti A, Del Principe MI,
Maurillo L, Buccisano F, Tamburini A, Cox MC, Franchi A, Bruno A,
Mazzone C, et al: Amount of spontaneous apoptosis detected by
Bax/Bcl-2 ratio predicts outcome in acute myeloid leukemia (AML).
Blood. 101:2125–2131. 2003. View Article : Google Scholar : PubMed/NCBI
|
|
8
|
Lagadinou ED, Sach A, Callahan K, Rossi
RM, Neering SJ, Minhajuddin M, Ashton JM, Pei S, Grose V, O'Dwyer
KM, et al: BCL-2 inhibition targets oxidative phosphorylation and
selectively eradicates quiescent human leukemia stem cells. Cell
Stem Cell. 12:329–341. 2013. View Article : Google Scholar : PubMed/NCBI
|
|
9
|
Stubbins RJ, Francis A, Kuchenbauer F and
Sanford D: Management of acute myeloid leukemia: A review for
general practitioners in oncology. Curr Oncol. 29:6245–6259. 2022.
View Article : Google Scholar : PubMed/NCBI
|
|
10
|
Guerra VA, DiNardo C and Konopleva M:
Venetoclax-based therapies for acute myeloid leukemia. Best Pract
Res Clin Haematol. 32:145–153. 2019. View Article : Google Scholar : PubMed/NCBI
|
|
11
|
Chen WL, Hsu YJ, Tsai WC and Tsao YT: An
unusual case of febrile neutropenia: Acute myeloid leukemia
presenting as myeloid sarcoma of the spleen. J Natl Med Assoc.
100:957–959. 2008.PubMed/NCBI
|
|
12
|
Arber DA, Orazi A, Hasserjian R, Thiele J,
Borowitz MJ, Le Beau MM, Bloomfield CD, Cazzola M and Vardiman JW:
The 2016 revision to the World Health Organization classification
of myeloid neoplasms and acute leukemia. Blood. 127:2391–2405.
2016. View Article : Google Scholar : PubMed/NCBI
|
|
13
|
Alaggio R, Amador C, Anagnostopoulos I,
Attygalle AD, Araujo IBO, Berti E, Bhagat G, Borges AM, Boyer D,
Calaminici M, et al: The 5th edition of the World Health
Organization Classification of Haematolymphoid Tumours: Lymphoid
Neoplasms. Leukemia. 36:1720–1748. 2022. View Article : Google Scholar : PubMed/NCBI
|
|
14
|
Xie XY, Filie AC, Jasper GA, Fukushima PI
and Stetler-Stevenson M: Diagnosis of unexpected acute myeloid
leukemia and chronic lymphocytic leukemia: A case report
demonstrating the perils of restricted panels in flow cytometric
immunophenotyping. Cytometry. 42:114–117. 2000. View Article : Google Scholar : PubMed/NCBI
|
|
15
|
Miller MK, Strauchen JA, Nichols KT and
Phelps RG: Concurrent chronic lymphocytic leukemia cutis and acute
myelogenous leukemia cutis in a patient with untreated CLL. Am J
Dermatopathol. 23:334–340. 2001. View Article : Google Scholar : PubMed/NCBI
|
|
16
|
Muta T, Okamura T and Niho Y: Acute
myelogenous leukemia concurrent with untreated chronic lymphocytic
leukemia. Int J Hematol. 75:187–190. 2002. View Article : Google Scholar : PubMed/NCBI
|
|
17
|
Ornellas De Souza MH, de Souza Fernandez
T, Diamond HR, Maioli MC, Pitanga Bacha PC and De Lucena SB:
Cytogenetic and immunophenotypic evidence of independent clonal
origins of concomitant chronic lymphocytic leukaemia and acute
myeloid leukaemia. Eur J Haematol. 66:281–283. 2001. View Article : Google Scholar : PubMed/NCBI
|
|
18
|
Lu CM, Murata-Collins JL, Wang E, Siddiqi
I and Lawrence H: Concurrent acute myeloid leukemia with
inv(16)(p13.1q22) and chronic lymphocytic leukemia: Molecular
evidence of two separate diseases. Am J Hematol. 81:963–968. 2006.
View Article : Google Scholar : PubMed/NCBI
|
|
19
|
Gottardi M, Gattei V, Degan M, Bomben R,
Zucchetto A, Tecchio C, Laurino L, Zanatta L, Dei Tos AP,
Mordacchini M, et al: Concomitant chronic lymphocytic leukemia and
acute myeloid leukemia: Evidence of simultaneous expansion of two
independent clones. Leuk Lymphoma. 47:885–889. 2006. View Article : Google Scholar : PubMed/NCBI
|
|
20
|
Chen RR, Zhu LX, Wang LL, Li XY, Sun JN,
Xie MX, Zhu JJ, Zhou D, Li JH, Huang X, et al: Synchronous
diagnosis and treatment of acute myeloid leukemia and chronic
lymphocytic leukemia: Two case reports. World J Clin Cases.
9:9144–9150. 2021. View Article : Google Scholar : PubMed/NCBI
|
|
21
|
Shoyele O and Gupta G: Synchronous
Diagnosis of de novo acute myeloid leukemia with inv(16)(p13q22)
and chronic lymphocytic leukemia: A case report and review of the
literature. Ann Clin Lab Sci. 48:790–796. 2018.PubMed/NCBI
|
|
22
|
Katz JB, Curran AL, Zemba-Palko V, Dabrow
MB and Denshaw-Burke MT: Synchronous diagnosis of chronic
lymphocytic leukemia and acute myeloid leukemia. J Clin Oncol.
28:e726–e728. 2010. View Article : Google Scholar : PubMed/NCBI
|
|
23
|
Zhang R, Kim YM, Lu X, Wang X, Pang H, Li
Y, Li S and Lee JY: Characterization of a novel t(2;5;11) in a
patient with concurrent AML and CLL: A case report and literature
review. Cancer Genet. 204:328–333. 2011. View Article : Google Scholar : PubMed/NCBI
|
|
24
|
DeFilipp Z, Huynh DV, Fazal S and Sahovic
E: Allogeneic stem cell transplantation for acute myeloid leukemia
with del(7q) following untreated chronic lymphocytic leukemia.
Hematol Oncol Stem Cell Ther. 5:165–168. 2012. View Article : Google Scholar : PubMed/NCBI
|
|
25
|
Kajtár B, Rajnics P, Egyed M and Alizadeh
H: Case report: Concomitant chronic lymphocytic leukaemia and
cytogenetically normal de novo acute leukaemia in a patient. Ann
Clin Lab Sci. 45:602–606. 2015.PubMed/NCBI
|
|
26
|
Milosevic I: Coexistence of chronic
lymphocytic leukemia and acute myeloid leukemia. Turk J Haematol.
33:353–354. 2016. View Article : Google Scholar : PubMed/NCBI
|
|
27
|
Licci S: Concurrence of chronic
lymphocytic leukaemia/small lymphocytic lymphoma and acute myeloid
leukaemia in a bone marrow biopsy. Pol J Pathol. 71:285–287. 2020.
View Article : Google Scholar : PubMed/NCBI
|
|
28
|
Al Mussaed E, Osman H and Elyamany G:
Simultaneous existence of acute myeloid leukemia and chronic
lymphocytic leukemia: A case report. BMC Cancer. 16:7392016.
View Article : Google Scholar : PubMed/NCBI
|
|
29
|
Ito S, Fujiwara SI, Mashima K, Umino K,
Minakata D, Nakano H, Yamasaki R, Kawasaki Y, Sugimoto M, Ashizawa
M, et al: Development of acute myeloid leukemia in patients with
untreated chronic lymphocytic leukemia. Ann Hematol. 96:719–724.
2017. View Article : Google Scholar : PubMed/NCBI
|
|
30
|
Lee HY, Park CJ, You E, Cho YU, Jang S and
Seo EJ: A case of acute myeloid leukemia concurrent with untreated
chronic lymphocytic leukemia. Ann Lab Med. 37:336–338. 2017.
View Article : Google Scholar : PubMed/NCBI
|
|
31
|
Kiso S, Sugiura H, Kuroi T, Omote R, Toji
T, Ishikawa T, Okamoto S, Nomura N, Masunari T, Sezaki N, et al:
Concurrent onset of chronic lymphocytic leukemia and atypical
phenotype acute myeloid leukemia revealed by autopsy. Case Rep
Oncol. 14:1725–1732. 2021. View Article : Google Scholar : PubMed/NCBI
|
|
32
|
Boddu P, Schlette E, Thakral B, Tang G,
Pemmaraju N, Kadia T, Ferrajoli A, Ravandi F, Wierda W and Jain N:
Acute promyelocytic leukemia in a patient with chronic lymphocytic
leukemia-A case report. Hematol Oncol Stem Cell Ther. 12:161–165.
2019. View Article : Google Scholar : PubMed/NCBI
|
|
33
|
Su J, Veillon D, Shackelford R, Cotelingam
J, El-Osta H, Mills G, Munker R and Devarakonda S: Acute
promyelocytic leukemia and chronic lymphocytic leukemia:
Concomitant presentation of two molecularly distinct entities. J La
State Med Soc. 169:68–70. 2017.PubMed/NCBI
|
|
34
|
Forconi F and Moss P: Perturbation of the
normal immune system in patients with CLL. Blood. 126:573–581.
2015. View Article : Google Scholar : PubMed/NCBI
|
|
35
|
Stengel A, Kern W, Haferlach T,
Meggendorfer M, Fasan A and Haferlach C: The impact of TP53
mutations and TP53 deletions on survival varies between AML, ALL,
MDS and CLL: an analysis of 3307 cases. Leukemia. 31:705–711. 2017.
View Article : Google Scholar : PubMed/NCBI
|
|
36
|
Graf T: Differentiation plasticity of
hematopoietic cells. Blood. 99:3089–3101. 2002. View Article : Google Scholar : PubMed/NCBI
|
|
37
|
Mato AR, Roeker LE, Jacobs R, Hill BT,
Lamanna N, Brander D, Shadman M, Ujjani CS, Yazdy MS, Perini GF, et
al: Assessment of the efficacy of therapies following venetoclax
discontinuation in CLL Reveals BTK inhibition as an effective
strategy. Clin Cancer Res. 26:3589–3596. 2020. View Article : Google Scholar : PubMed/NCBI
|
|
38
|
Bewersdorf JP, Giri S, Wang R, Williams
RT, Tallman MS, Zeidan AM and Stahl M: Venetoclax as monotherapy
and in combination with hypomethylating agents or low dose
cytarabine in relapsed and treatment refractory acute myeloid
leukemia: A systematic review and meta-analysis. Haematologica.
105:2659–2663. 2020. View Article : Google Scholar : PubMed/NCBI
|
|
39
|
Held L, Siu C and Shadman M: Venetoclax as
a therapeutic option for the treatment of chronic lymphocytic
leukemia: The evidence so far. Expert Opin Pharmacother.
22:655–665. 2021. View Article : Google Scholar : PubMed/NCBI
|
|
40
|
Seymour JF, Kipps TJ, Eichhorst B, Hillmen
P, D'Rozario J, Assouline S, Owen C, Gerecitano J, Robak T, De la
Serna J, et al: Venetoclax-Rituximab in relapsed or refractory
chronic lymphocytic leukemia. N Engl J Med. 378:1107–1120. 2018.
View Article : Google Scholar : PubMed/NCBI
|